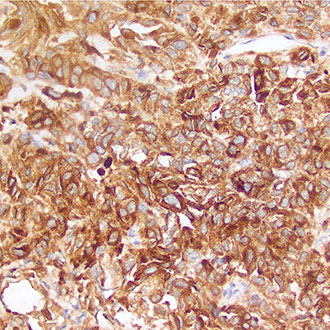
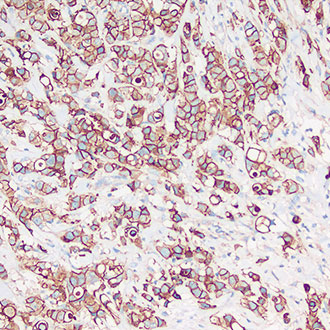

-
 Cyclin D1
Cyclin D1 -
 p63
p63 -
 CK7
CK7 -
 CK20
CK20 -
 CK5&6
CK5&6 -
 Ki-67
Ki-67 -
 CD8
CD8 -
 CD5
CD5 -
 TTF-1
TTF-1 -
 p40
p40 -
 CD34
CD34 -
 CK19
CK19 -
 p16
p16 -
 S100
S100 -
 CD30
CD30 -
 PMS2
PMS2 -
 CD3
CD3 -
 CK(HMW)
CK(HMW) -
 CD56
CD56 -
 CD10
CD10 -
 Vimentin
Vimentin -
 Synaptophysin
Synaptophysin -
 p53
p53 -
 EGFR
EGFR -
 AMACR
AMACR -
 SMA
SMA -
 EMA
EMA -
 bcl-6
bcl-6 -
 D2-40
D2-40 -
 WT1
WT1 -
 MLH1
MLH1 -
 CD79a
CD79a -
 Napsin A
Napsin A -
 CD31
CD31 -
 CDX-2
CDX-2 -
 bcl-2
bcl-2 -
 CK Pan
CK Pan -
 AR
AR -
 CD45
CD45 -
 CD138
CD138 -
 MSH6
MSH6 -
 GFAP
GFAP -
 SOX-10
SOX-10 -
 CD68
CD68 -
 CAM5.2
CAM5.2 -
melan A
melan A -
 Pax-8
Pax-8 -
 CD1a
CD1a -
 CD45RO
CD45RO -
E-Cadherin
E-Cadherin -
 MUM1
MUM1 -
 GATA3
GATA3 -
 CD21
CD21 -
 Calretinin
Calretinin -
 PSA
PSA -
 CD23
CD23 -
 ERG
ERG -
 Pax-5
Pax-5 -
 EZH2
EZH2 -
 MSH2
MSH2







 沪公网安备31012002005577号
沪公网安备31012002005577号